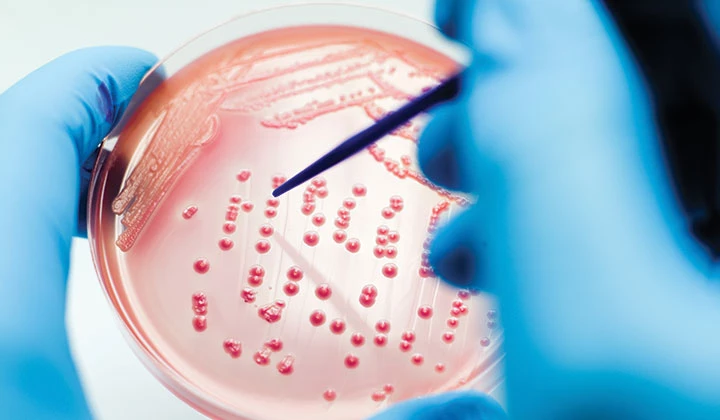

Hautpilz & Symptome
Anzeichen einer Pilzinfektion richtig deuten
Geschätzte Lesedauer: 1 Min.
Eine Pilzinfektion ist schnell passiert. Denn die mikroskopisch winzigen Pilzsporen finden sich auf und in unserem Körper. Umso schwieriger kann es allerdings sein, einen Pilzbefall frühzeitig und eindeutig festzustellen. Welche ersten Anzeichen und konkreten Symptome auf Hautpilz hinweisen, erfahren Sie hier.
Hautpilz: Symptome frühzeitig erkennen
Ein gesundes Immunsystem verhindert normalerweise, dass sich Hautpilze übermäßig stark in unserem Organismus vermehren.
Sind unsere Abwehrkräfte allerdings geschwächt, besteht die Gefahr einer Mykose. Symptome zeigen sich relativ schnell und eine Pilzinfektion der Haut entsteht. Vor allem in feucht-warmen Hautfalten, bei Wärmestau unter Kunstfasern oder in dicht schließenden Höschenwindeln, finden Hautpilze perfekte Lebensbedingungen.
Doch Pilzinfektion-Symptome sind nicht immer eindeutig. Der Hautarzt kann eine Hautmykose jedoch zuverlässig durch einen Abstrich diagnostizieren.
Konkrete Symptome einer Pilzinfektion
Hautpilz-Symptome lassen sich beispielsweise daran festmachen, dass bestimmte Stellen auf der Haut gerötet sind und jucken. Die geröteten Stellen befinden sich vornehmlich…

-
...in Hautfalten
-
...in der Leistengegend
-
...unter den Achseln
-
...in den Kniekehlen
-
...zwischen den Zehen
-
...unter den Zehennägeln
-
...unter den Brüsten
-
...am After / in der Pofalte
Außerdem können Sie Hautpilz-Symptome daran ausmachen, dass Ihre Zunge einen weißen Belag hat. Auch Erkrankungen, wie Diabetes mellitus, immundämpfende Medikamente oder häufige Erkältungen können Symptome einer Pilzinfektion sein. Ein weiteres Anzeichen für Hautpilz ist Heißhunger auf süße oder kohlenhydrathaltige Speisen.
Treffen einer oder mehrere Fälle auf Sie zu, sollten Sie mit Ihrem Arzt eine mögliche Pilzinfektion abklären.

Multilind® Heilsalbe
Die Kombination aus Nystatin & Zinkoxid lindert den Juckreiz und hemmt die Entzündung betroffener Hautstellen.
Weitere interessante Artikel